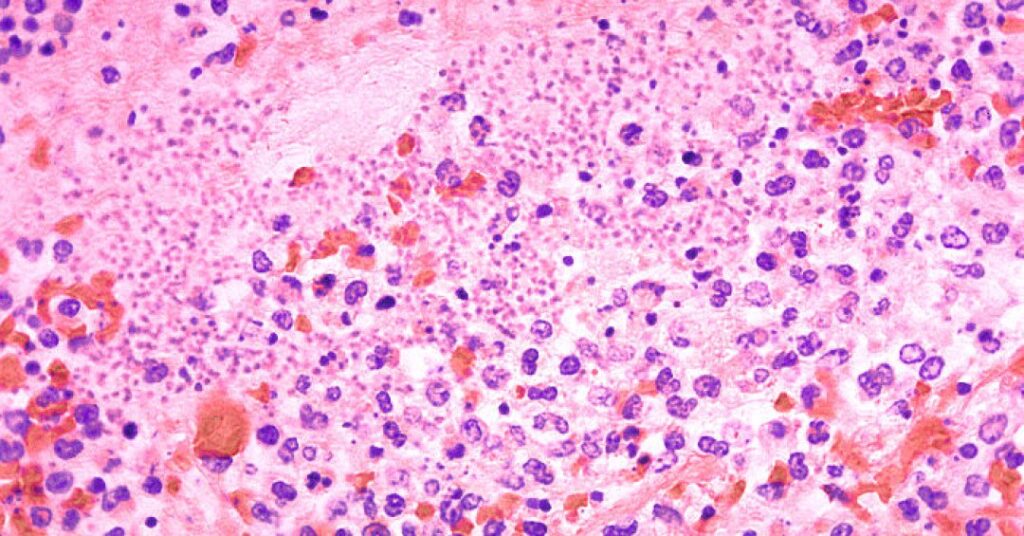

Autoridades sanitárias do Arizona, nos Estados Unidos, confirmaram a morte de uma pessoa em função da peste pneumônica, uma doença “prima” da peste bubônica e causada pela mesma bactéria, a Yersinia pestis.
O caso foi notificado na última sexta-feira (11), sem dar detalhes – como sexo, idade ou comorbidades – do paciente. De acordo com as informações oficiais, é o primeiro caso de peste registrado no condado de Coconino, onde a pessoa vivia, desde 2007.
+ Leia também: A peste bubônica pode voltar a ameaçar o mundo (e o Brasil)?
O que é a peste pneumônica?
A peste pneumônica é um dos tipos de infecção possíveis pela Yersinia pestis, bactéria famosa pela peste bubônica, que matou milhões de pessoas na Europa durante a Idade Média.
Como o nome sugere, a versão pneumônica da doença acomete os pulmões. Ela é a mais rara, mas também é considerada a mais letal das doenças causadas por essa bactéria, levando a uma pneumonia grave que, com frequência, culmina em falência respiratória.
O tratamento deve ser feito com antibióticos, que podem ser orais ou intravenosos conforme a gravidade do caso. A intervenção deve ser feita o mais rapidamente possível, já que a progressão da doença pulmonar é muito rápida e o tratamento pode não ser iniciado a tempo de salvar o paciente, como parece ter sido o caso no Arizona.
Qual a diferença para a peste bubônica?
Todos os tipos de peste são causados pela bactéria Yersinia pestis. De modo geral, as principais diferenças entre a peste pneumônica e a bubônica dizem respeito à parte do corpo acometida pela infecção e ao modo de contágio.
A peste bubônica é caracterizada pela infecção e inchaço dos linfonodos, enquanto a pneumônica ataca os pulmões. Muito mais comum (e com mais chance de sobrevivência), a bubônica é causada pela mordida de pulgas infectadas pela bactéria. Já a pneumônica costuma ocorrer pela inalação de gotículas de saliva ou respiratórias vindas de um animal ou de uma pessoa infectada.
Nos EUA, o último caso registrado de peste pneumônica transmitida de humano para humano ocorreu em 1924. Por isso, a suspeita das autoridades é que o novo caso tenha vindo de um animal.
Além da bubônica e da pneumônica, também existe a peste septicêmica, que ocorre quando a Yersinia pestis entra na corrente sanguínea, seja pela mordida das pulgas ou pelo contato de ferimentos abertos com fluidos de animais infectados. Sem tratamento, essa versão pode causar gangrenas e falência de órgãos internos.
Compartilhe essa matéria via:
Fonte.:Saúde Abril